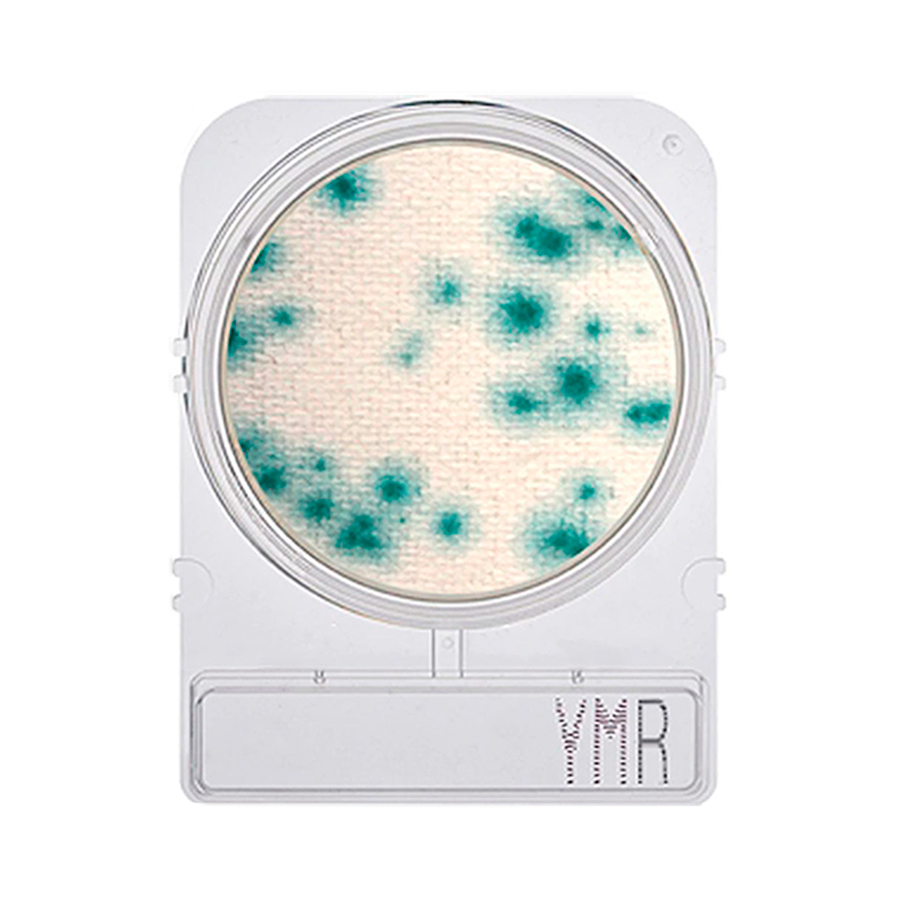
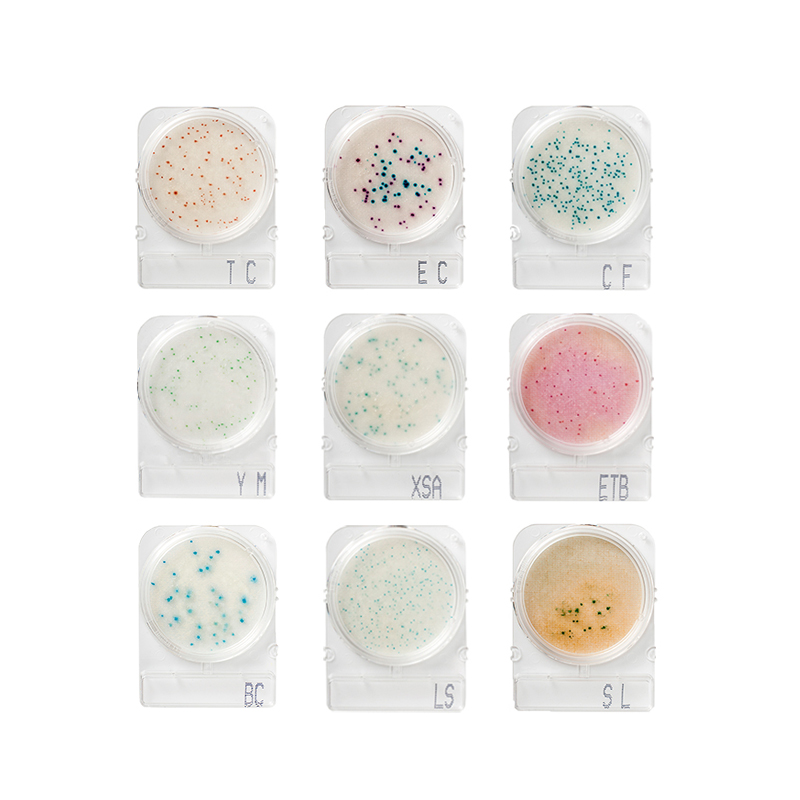

Rastreamento de Cargas
(*) Quando o remetente ou o destinatario for pessoa fisica, adicionar "000" (3 zeros) antes do numero do CPF.

(*) Quando o remetente ou o destinatario for pessoa fisica, adicionar "000" (3 zeros) antes do numero do CPF.
Compact Dry YM – Bolores e Leveduras
Temperatura:
Tempo:
Compact Dry são placas prontas para detecção e quantificação microbiológicas em matérias-primas, alimentos e ambiente. É um método de ensaio microbiológico pronto para uso que permite uma perfeita absorção das amostras inoculadas. Permite quantificar a maioria das bactérias de interesse para a indústria alimentícia.
Maior agilidade e praticidade para análises; pronto para uso: aumento da capacidade analítica do laboratório; redução de materiais auxiliares e desperdícios; redução de 90% do espaço ocupado para estocagem e incubação; redução de erro analítico; resultados rápidos e precisos; apenas 3 passos: inoculação, incubação e leitura; esterilizadas individualmente; embalagem ecológica e com 100 placas; tecnologia da Alemanha.
Entre em contato conosco atráves de um representante ou envie um e-mail pela aba contato.
Fale conosco